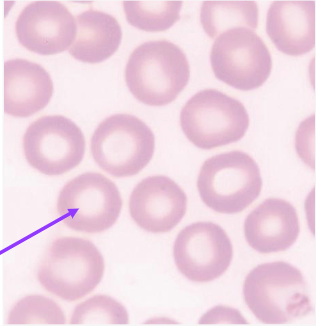
<p>Biconcave shape which creates a central pallor and high surface:volume ratio</p>
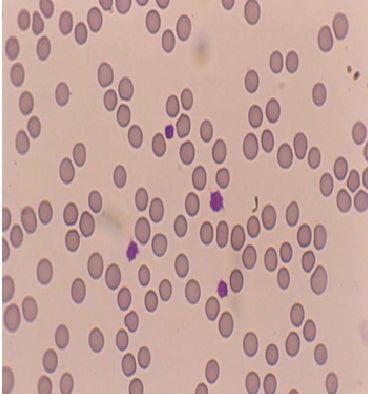
knowt flashcard image
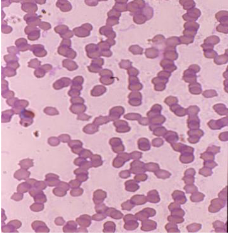
knowt flashcard image
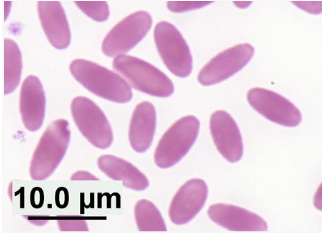
knowt flashcard image
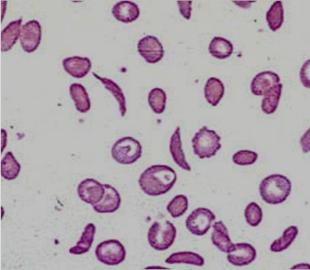
knowt flashcard image
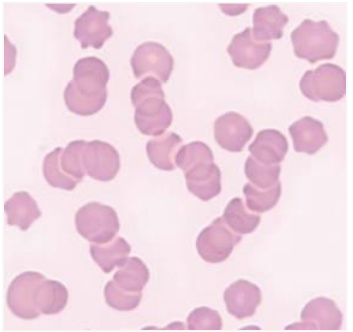
<p>Equine erythrocytes form rouleaux easily; even in healthy horses</p>
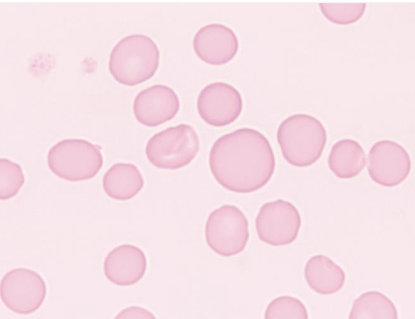
knowt flashcard image
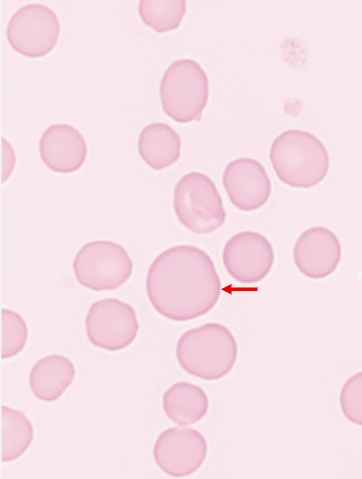
knowt flashcard image
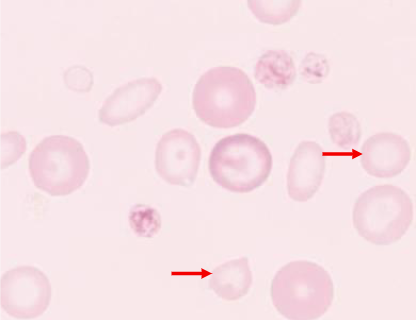
knowt flashcard image
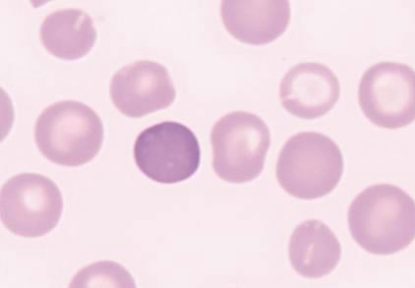
knowt flashcard image
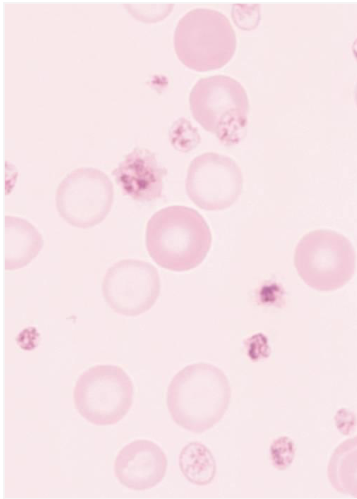
knowt flashcard image
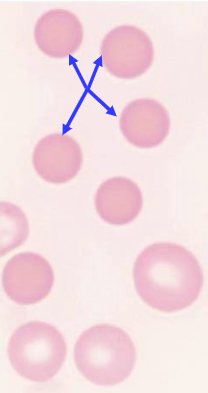
knowt flashcard image
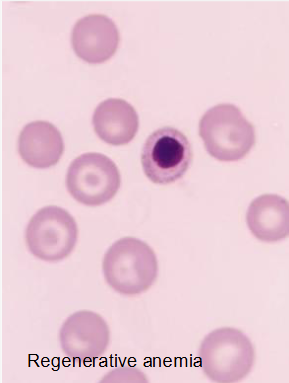
knowt flashcard image
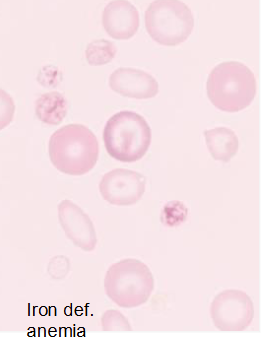
<p></p>
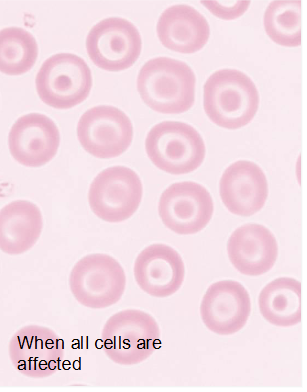
knowt flashcard image
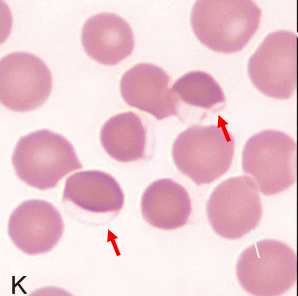
knowt flashcard image
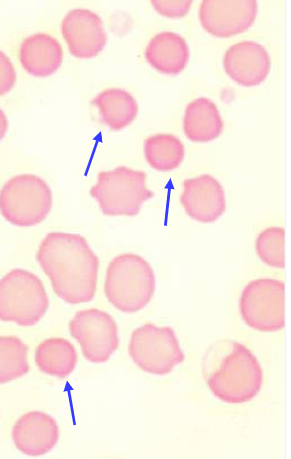
knowt flashcard image

RBC Morphology and Blood groups
1/79
There's no tags or description
Looks like no tags are added yet.
Name | Mastery | Learn | Test | Matching | Spaced | Call with Kai |
|---|
No analytics yet
Send a link to your students to track their progress
80 Terms
Iron in the blood:
Iron is transported into blood, stored in bone erythrocytes and macrophages in bone marrow, spleen and liver
effected by anemia and cytokines
What is the function of iron in the red blood cell?
Oxygen transport
Transferrin
negative acute protein phase
Cytokines decrease transferrin
How is Iron transported?
transported plasma bound to transferrin
What is the storage form of iron?
ferritin and hemosiderin
cytokines increase Fe stores
Characteristics of RBCs
Anucleate
Have repelling forces
Anaerobic metabolism
Morphologic Features of Erythrocytes
Biconcave shape which creates a central pallor and high surface:volume ratio
Blood Groups (Types)
Glycolipid & glycoprotein RBC surface antigens
Inherited, Immunogenic, Species-specific
Importance of Blood Groups in veterinary medicine
Blood transfusions
Diagnosis and characterization of disease
Parentage testing
Forensic science
Feline RBCs
Central pallor is not prominent
Lifespan in circulation is ~75 days
Morphology of Feline RBCs
Feline Blood Type A
Most common
have naturally occurring antibodies
Low titer anti-B hemagglutinins and hemolysins
Feline Blood Type B
Higher titer anti-A hemagglutinins and hemolysins
Characteristics of Canine RBCs
Prominent central pallor
lifespan in circulation ~120 days
Canine Blood type DEA 1.1
most antigenic and should be avoided
Canine Blood type DEA 4 positive
Universal donor
lack other antigens; however transfusion reactions can occur after multiple exposure(DEA 4 neg to pos) and DEA 1.1 negative dogs
Canine Blood type groups(Dog erythrocyte antigen)
DEA 1.1, 1.2, 1.3, DEA 4, DEA 3, 5, DEA 7, Dai, Kai
Morphology of canine RBCs
?????
Characteristics of Equine RBCs
Rouleaux formation – stack of coins
Lifespan in circulation is about 160 days
Equine blood groups(A,C,D,K,P,Q,U)
Blood group genes produce antigenic sites called factors, 30 + factors found (usually "a")
Donors need to be negative for antibodies to the factors: Most immunogenic: Aa, and Qa
Morphology of Equine RBCs
Bovine RBCs
Medium sized RBCs
MCV= 60 FL
Lifespan in circulation is about 140 days
Bovine blood groups
11 genetic systems recognized
Most important: EAJ-system
Serum and tissue antigen
Camelids RBCS
elliptical RBCS
Lack a central pallor
Blood groups(A,B,C,D,F)
Morphology of Camelid RBC
Morphology of Deer RBCs
Exotic RBCs
Large elliptical cell
Nucleated RBCs
Aerobic metabolism
Different exotic species lifespan in circulation
Avian 28 days
Amphibians 800 days
What is the best course of action in a neonatal foal that has clinical signs of neonatal Isoerythrolysis (moderate hemolytic anemia)?
D. Withhold colostrum from the foal
What are important characteristics of RBC morphology?
Density and distribution
Shape
Size
Color
Rouleau: roll of coins
cells lose repelling force
Seen mostly with hyperglobulinemia and/or hyperfibrinogenemia
Usually due to inflammation &/or dehydration
Rouleau morphology
Equine erythrocytes form rouleaux easily; even in healthy horses
Agglutination Formation
antibodies form bridges between RBCs

Significance of agglutination
Immune-mediated anemias
Interferes with cell counting and sizing methods
Clumps seen as large RBCs(decrease [RBC] & increase MCV)
Saline agglutination test (SAT)
Failure to disperse= IMHA(Immune-Mediated Hemolytic Anemia)
Dispersion = dehydration and/ or inflammation
Anisocytosis
due to presence of macrocytes, discocytes, microcytes
Significance: Regenerative anemia
morphology of Anisocytosis
Macrocytosis Formation:
incomplete maturation or skipped cell division
Macrocytosis significance
Regenerative anemia
Correlates with ↑ Mean Cell Volume (MCV)
Best evidence of RBC regeneration in horses
Poodle dyscrasia
Morphology of Macrocytosis
Microcytosis
Results from increase in cell divisions
Significance of Microcytosis
Fe deficiency due to chronic blood loss
Correlates with ↓MCV
Breed variation: Akita, shiba
Age variation: foals <6months
Morphology of Microcytosis
Polychromatophilic Erythrocyte
Formation: accelerated erythropoiesis
Significance of Polychromatophilic Erythrocyte
Regenerative anemia
Purple color is caused by RNA
Immature stage before normocyte is released from bone marrow
Morphology of Polychromatophilic Erythrocyte
Ways to detect Polychromatophilic Erythrocyte
Polychromatophils on Diff Quik Stain
Reticulocytes via new methylene blue stain
Hypochromic Erythrocyte
Formation: incomplete Hgb synthesis
Increased central pallor
Significance of Hypochromic Erythrocyte
Regenerative anemia
↓MCHC (Mean cell hemoglobin concentration)
Morphology of Hypochromic Erythrocyte

Hypochromic Erythrocyte Pt. II
Formation: defective Hgb synthesis due to lack of Fe
Significance of Hypochromic Erythrocyte pt. II
Chronic blood loss leading to Fe def
↓MCHC
Morphology of hypochromic Erythrocyte Pt. II
4-year-old female mixed breed dog is presented with pale mucous membranes. Blood smear had uneven distribution of erythrocytes with low density erythrocytes, moderate anisocytosis and many microcytosis. What is the most probable cause of these findings?
C. Fe-deficiency
What term best describes abnormal shapes of erythrocytes?
E. Poikilocytosis
Echinocyte(echino- = spiny)
Formation: alkaline pH of glass leads to membrane changes
Significance of Echinocyte
Slow drying artifact= crenated RBCs
Hyponatremic dehydration
Rattlesnake venom
Morphology of Echinocytes

Spherocyte(sphero=round)
removal of membrane or defective membrane
Significance of Spherocytes
Immune-mediated hemolysis
Macrophages in the spleen remove membrane coated with antibodies causing cell to change from discocytes to spheroid shape
Seen only in Dogs
Morphology of Spherocytes
Codocytes: young eryrthrocytes
Codocytes: hypochromasia
Codocytes: liver disease
Schizocyte formulation
intravascular RBC trauma
Schizocytosis seen in:
Microangiopathy
Intravascular coagulation (fibrin strands)
Vasculitis
Morphology of Schizocytes

Keratocyte formulation
intravascular RBC trauma
Significance of Keratocyte
Microangiopathy
Intravascular coagulation (fibrin strands)
Vasculitis
Morphology of Keratocyte

Eccentrocyte formulation
oxidative damage to RBC membrane
Eccentrocytosis significance
overwhelming exposure to oxidants
Morphology of Eccentrocyte
Pyknocyte formulation
oxidative damage to membrane and hgb
Significance of Pyknocytes
overwhelming exposure to oxidants
(similar to Heinz body anemias)
hereditary defects in RBC enzymes
Morphology of Pyknocytes
Inclusion bodies: Heinz Bodies formulation
oxidative damage to Hgb
Oxidants overwhelm reductive capacity
In anaerobic glycolysis (Fe2+ --- Fe3+ causing precipitation of Fe on membrane)
Significance of Heinz bodies
Heinz body anemias
Examples: acetaminophen, onions, red maple leaves, zinc toxicosis
Cats different – common due to their HgB structure
Morphology of Heinz bodies

7-year-old dog with pale mucous membranes is presented. Blood film has uneven distribution, low density erythrocytes, moderate anisocytosis, macrocytosis, and occasional Heinz bodies. What pathologic process is most likely?
D. Oxidative damage to hemoglobin